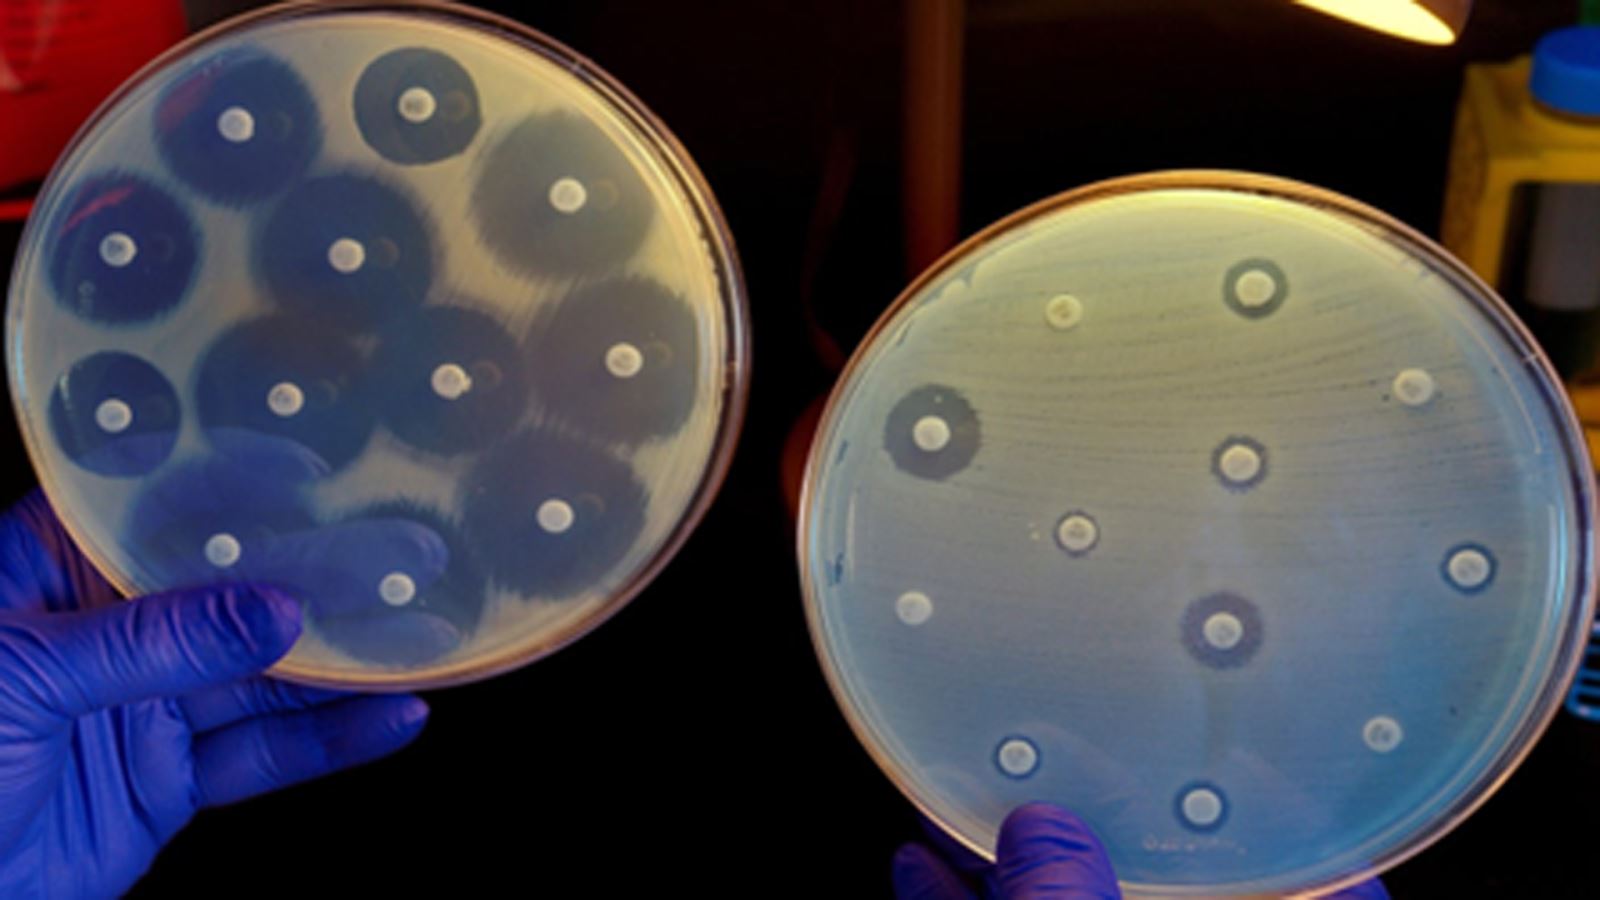
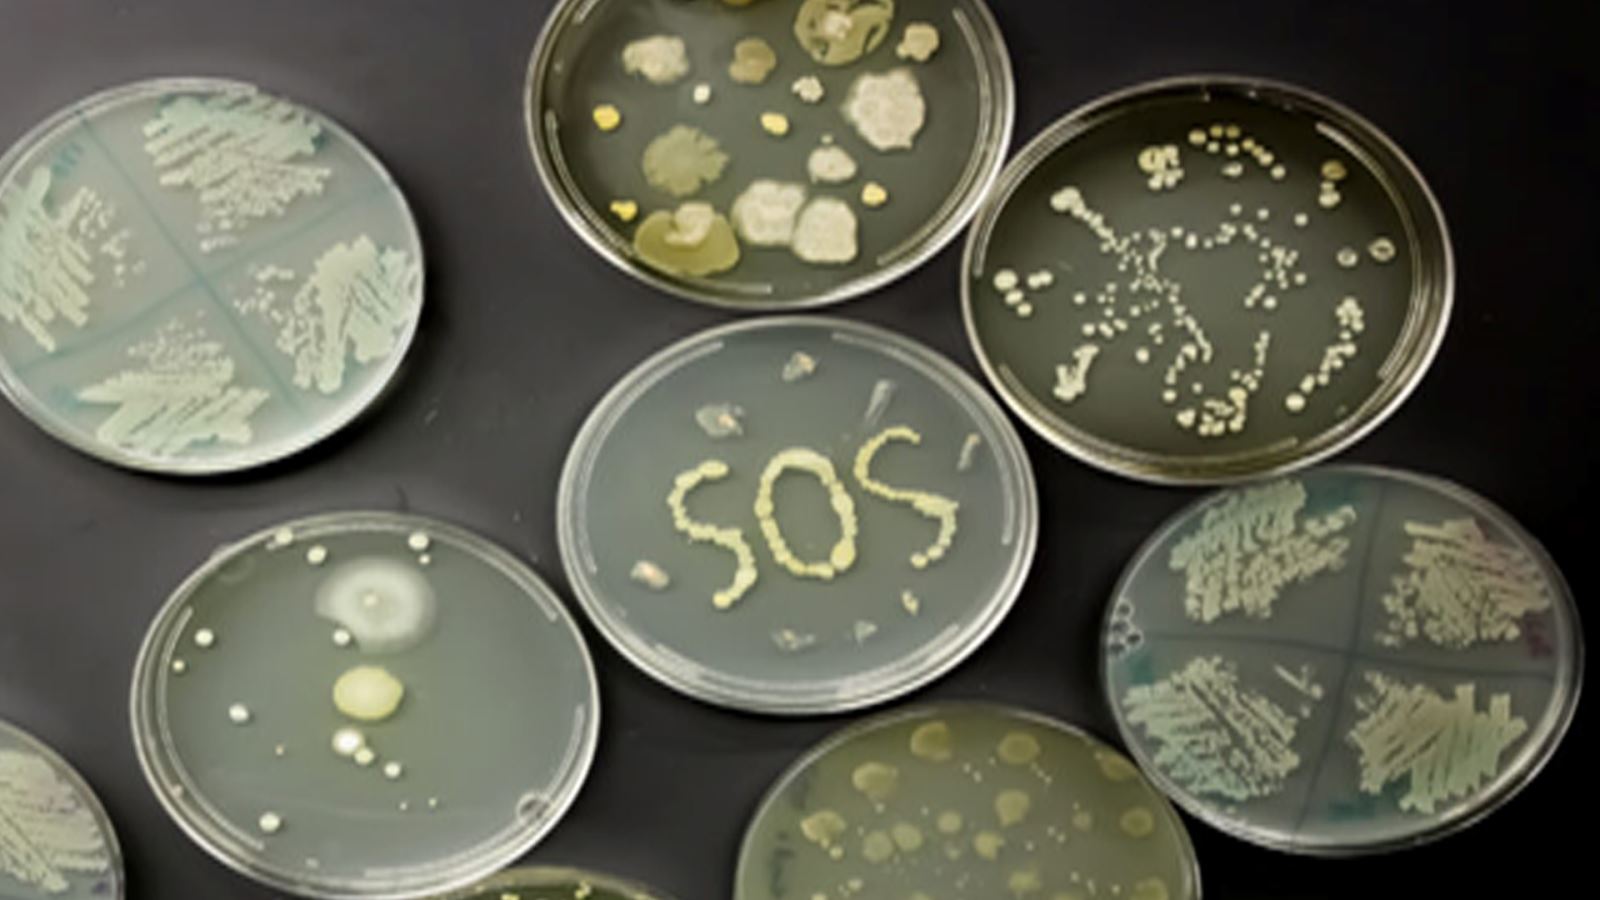

0
25/07/2023
Các giải pháp hiện tại được sử dụng phổ biến: kháng sinh; hóa chất; thảo dược tự phát
Việc đánh hóa chất khi vibrio trong ao đang vượt ngưỡng, tôm đang bệnh giúp giảm nhanh mật độ khuẩn bệnh trong nước ao nhưng không có tác dụng chữa bệnh cho tôm, đồng thời lại tiêu diệt toàn bộ hệ vi sinh có lợi gây mất cần bằng sinh học, gián đoạn các chu trình chuyển hóa chất ô nhiễm trong ao, gây độc và tạo thêm stress môi trường sống cho tôm khi đang bị bệnh.
Việc sử dụng thảo dược tự phát chưa được nghiên cứu, tính toán liều lượng phù hợp, chế biến thô sơ, không qua công đoạn bào chế, tính sinh khả dụng thấp dẫn đến hiệu quả chưa cao. Bên cạnh đó việc thu mua, sơ chế, chế biến, bảo quản và sử dụng thảo dược tự phát có thể ẩn chứa nhiều nguy cơ như nấm mốc có hại, nhiễm tạp, một số độc tính có sẵn của thảo dược chưa được loại bỏ hoàn toàn gây nguy hiểm cho cả ao tôm.
Giải pháp phổ biến nhất và cũng là vấn nạn ở Việt Nam hiện nay là sử dụng kháng sinh. Kháng sinh sẽ cho hiệu quả cao nếu được dử dụng đúng, tuy nhiên thực tế việc sử dụng kháng sinh không đúng cách kéo dài lâu nay ở nhiều địa phương trên cả nước đang gây nên tình trạng kháng kháng sinh nghiêm trọng. Ngoài ra, dư lượng kháng sinh còn tồn dư trong cơ thể tôm sẽ ảnh hưởng đến sức khỏe của người tiêu dùng, ảnh hưởng đến việc xuất khẩu. Dùng kháng sinh để điều trị không đúng chủng loại, không đúng liều lượng, không đúng thời gian quy định hướng dẫn, vi khuẩn gây bệnh có điều kiện thích nghi và biến đổi chống lại các loại kháng sinh đã sử dụng gây nên hiện tượng kháng kháng sinh.

Đây là nguyên nhân lớn khiến cho việc điều trị bằng kháng sinh với các bệnh nhiễm khuẩn trên tôm không còn hiệu quả cao, dịch bệnh ngày càng khó kiểm soát do việc gia tăng vi khuẩn gây bệnh kháng thuốc. Theo Hồ Khánh Duy & cộng sự, 2019 gần 100% các chủng vi khuẩn (240 chủng vi khuẩn Vibrio) phân lập từ mẫu tôm nuôi thương phẩm và mẫu nước ao nuôi tại các tỉnh Long An, Bến Tre, Bạc Liêu, Tp. HCM, mẫu tôm giống thu tại tỉnh Bạc Liêu, Ninh Thuận đều thể hiện tính kháng với các loại kháng sinh Penicillin, Ampicillin, Oxacillin, Amoxicillin. Vibrio parahaemolyticus phân lập được từ các hệ thống nuôi tôm thẻ chân trắng ở Bạc Liêu có tỷ lệ kháng cao với Apramycin (73,3%) và nhạy cao nhất (100%) với Doxycyline và Chloramphenicol (Nguyễn Công Tráng & cộng sự, 2019). Người nuôi chỉ nên coi kháng sinh như biện pháp cuối cùng khi điều trị bệnh ở tôm.
Chính vì các lý do trên rất cần có một giải pháp sinh học bền vững trong phòng và điều trị bệnh gan tụy trên tôm có thể thay thế kháng sinh, hóa chất, trong tình hình các dịch bệnh diễn biến phức tạp, khó lường và cũng là để nâng cao năng lực cạnh tranh của con tôm Việt Nam với các nước khác trên thế giới.

Mới nhất